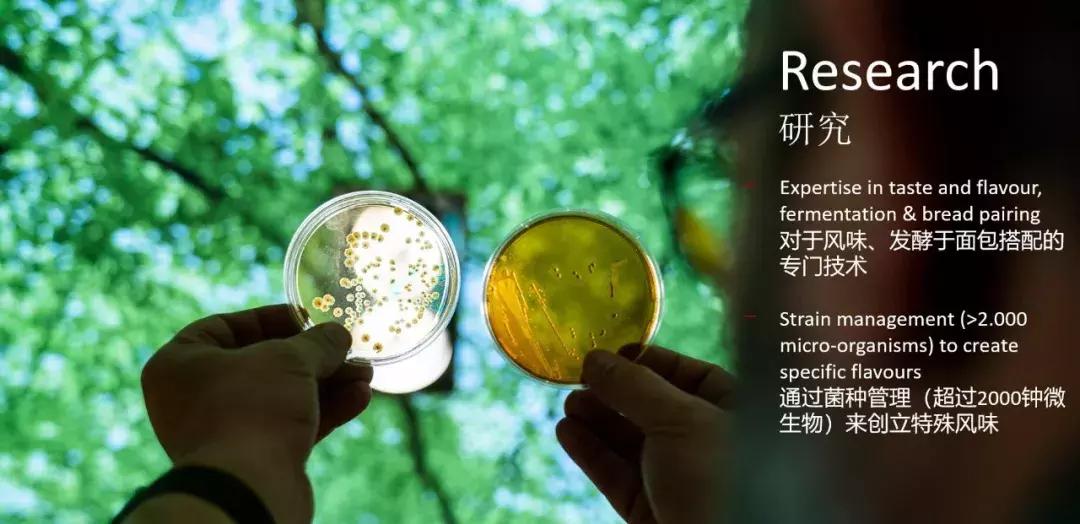
六国面包师的华山论剑,烘焙人最感兴趣的技术秘诀、开店运营

5月6日是上海烘焙展第一天,“六国面包技术商业互通”面包论坛圆满闭幕,论坛的主持人朋福东老师,也是这次代表中国的面包师与来自另外五个国家的代表面包师一起交流面包技术与商业。

另外五位面包大师分别是德国Olaf Mieth 、韩国 韩相柏、比利时 Pelegrín Josep M、法国 MOF Mickaël CHESNOUARD 、日本 土田耕正。

6位面包师,以“嗅觉、听觉、味觉、触觉、视觉”五感主题,围绕面包的发酵、风味来解析面包技术,并带来了技术转化商业的参考思路。
德国 Olaf Mieth

他是拥有超过25年烘焙经验的资深烘焙大师,同时他还是高材生拥有烘焙大师硕士学位。 2008年开始加入德国WIESHEU集团,负责烘焙培训、烘焙演示等。这次分享的主题是:“从嗅觉上丰富面包的香味”
1977年出生在德国
1994-1997年 期间接受烘焙培训
1997-2001年期间在多家面包房承担面包师工作 2002年在德累斯顿的Saxonia学校成功获取烘焙大师硕士学位
2000年开始作为一名烘焙大师及培训师在全世界范围进行服务
2008年开始加入德国WIESHEU集团,负责烘焙培训,销售研讨会,烘焙演示

Olaf带了德国面包给现场的观众品尝,也让大家更好地理解面包的香味、风味。如果眼睛是心灵的窗口,那么新鲜烘焙的面包产生的气味,则是敞开的门。味道风味,就是最强烈的感官。
丰富面包口味
如果直接食用酸面团很多人接受度不高,也可以考虑通过以下三种方式来丰富面团的风味。
1.黄油、牛奶、水果、巧克力,调整风味口感;

2.通过香料作用丰富面包的嗅觉吸引力:肉桂香草、可可粉、生姜茴香、香菜、肉蔻等,例如特殊香味代表的德国史多伦面包。

3.馅料里使用熏肉,火腿奶酪,迷迭香,橄榄等等香味浓郁的食材。

成功商业五大要素
如果你的店铺运营尚未成功,对比Olaf提出的以下5大要素,思考你是哪点做的不足。

针对不同受众群,德国有不同的面包品牌。
1.针对高端客户,为了最好的质量能够接受高价格,寻找更好配方配料,有机食物健康、当地特色,有故事的产品。
2.对于低预算,则出亲民系列产品,与高端差价40-50%之间。
韩国-韩相柏

他是韩焙机械科技(上海)有限公司----首席烘焙顾问、HANS DRENM 面包店首席烘焙师,法国世界面包大赛第四名。
日本 CHI BA DOLUCIA 蛋糕店任技术总监
在新世界总店DALLOYAU1 号店任技术总监
HIBAC 烘焙比赛金奖
全国核桃产品比赛银奖
中国广州亚洲面包世界杯(7 个国家和地区)1 等奖
全国技能竞技大赛烘焙评委
大邱,庆北制饼比赛技术领域会长
大韩制饼协会国际合作部会长
大韩制饼协会市场营销领域委员长
选拔烘焙国家代表教练及评委
韩相柏老师分享的主题是:“倾听面包唱歌,如何通过听觉判断面包状态,做烘焙时间和温度的调整”。
面包的声音有哪些?
搅拌:面团搅拌缸的摩擦声响
发酵:定时器的声响
分割:切割面团时,刮板
烘烤:喷蒸汽的声音
搅拌到烘焙的过程中,会让我们感受烘焙。不断地自己测试,形成经验,例如欧式面包刚烤出来测试成熟度,敲击声音来判断。
烘烤面包会根据水量不同,时间也不一样,一般水分多的面包,烘烤的时间也比较长,面包含馅料烘烤后含水量在10%,不含馅料的18%水分剩余。
烘焙市场面包的未来趋势
韩相柏老师在韩国釜山的面包店Hans Dream Bakery翻译过来就是韩师傅的面包梦想。
有梦想的烘焙师,年轻的时候是夜场DJ,后来转行从事面包,至今已经32年,面包改变了韩相柏的人生,他现在每年全球交流传播技术。韩相柏也分享他最初开店的故事-如何开一家盈利的面包店——到开一家自己梦想中的店?这也是他逐渐传播健康面包的理念,从而引导消费者的消费习惯的过程。

▲ 韩梦

开店初期:100%赚钱的面包店。
当初软面包最赚钱,毕竟亚洲都是软面包为主,开店资金不足,消费者市场导向为主,做到了20万日币的日营业额。
第二阶段:80%-20%
营业额提升至5倍,策略转向,80%软质面包,20%欧式面包。这个阶段的转变,也得益于韩相柏老师去参加比赛,得到优胜,个人想法也重新改变,面包不仅要好吃,也要为消费者着想,美味同时且健康。
第三阶段: 50%-50%
一半的软质面包,一半的健康欧式面包。
第四阶段:20%-80%
梦想的最终阶段,是20%软质,80%少油少糖的健康欧式面包。
刚开始开店的阶段,目标是店能够持续生存下去,而达到第二阶段,就可以陆续开始转变为做自己想做的面包店,但是每个阶段转变,需要根据自己店铺的实际情况。
成功代表着“END”,成长代表着“ING”,成长伴随着成功,韩相柏老师希望大家换一个观念,每日成长,相信你们也会伴随着成功。
比利时-Pelegrín Josep M

Pelegrín Josep M是焙乐道亚太区研发总监,毕业于巴塞罗那大学生物化学专业,主修医药产品制造。在制药和食品行业有过不同的经验后,Josep于2003年加入焙乐道(始创于1919,真正的百年企业)
Pelegrín Josep M来自西班牙赫罗纳。
毕业于巴塞罗那大学生物化学专业,主修医药产品制造。
在制药和食品行业有过不同的经验后,Josep于2003年加入焙乐道西班牙公司,担任面包类的研发经理。
2009年 他被调到布鲁塞尔,担任面包类研发经理,负责东欧、俄罗斯、中东、印度和澳大利亚的研发支持。
2013年他作为意大利焙乐道的研发经理搬到意大利,在那里他帮助发展了业务并建立了一个伟大的烘焙研发团队。
2017他被任命为亚太研发总监,移居香港,领导和协调着11个国家的产品研发活动。
Pelegrín Josep M对面包和酸面团有着浓厚的热情,在面包和糕点行业有着丰富的经验。
分享主题是:“面包的未来就在它的过去,全球天然发酵风味的研究与应用”

通过在过去20年的消费者的购买面包的数据发现,消费者更倾向购买传统、经典的面包。而传统的面包风味来源的秘诀,就在于发酵。发酵技术可能是一项比使用火更伟大的发明。

发酵的食物、饮料有:葡萄酒、火腿、橄榄、面包、芝士,但是唯有面包是便宜的,而我们则是努力提高面包的价值。

酸面团在欧洲非常受欢迎,在亚洲酸不太能接受,但是其实和中国老面异曲同工——面粉和水混合、膨胀、烘烤出美味发酵食品。

酸面团的基本过程
在中国,酸面团(老面)用于传统风味的馒头,已经有很长的历史了。商业酵母促进烘焙行业的进步,却也让烘焙师逐渐忘记了传统的酸面团技术。因为商业烘焙酵母的的普及、最佳的便利性,使得酸面团的传统逐渐丢失了。许多面包师改用烘焙酵母,因为酸面团很难控制均一品质、出品效率也更低。
如今消费者再次期待着传统而富有风味的酸面团用于烘焙产品,而现代技术的创新融入,也方便了其使用。酸面团面包新产品开始迅速增长,2016-2017有30%的增长,互联网中酸面团的搜索量也成倍增加。

▲过去5年的搜索数据
酸面团的发展
20年前,酸面团=?
10年前,酸面团=味道
现在,酸面团=味道+质构
未来10年,酸面团:味道、质构、消化
食用酸面团更容易消化和吸收,更加健康的酸面包销量开始递增。


在全世界寻找独特酸面团和传统烘焙之旅,使Pelegrín Josep 对发酵有了深刻的理解。焙乐道在比利时小镇,建立了一个面包风味中心,邀请顾客访问,探讨面包风味、质构的变化。其中酸面团收藏馆中已经有115个酸面团的收藏,恒定的温度,还有专人蓄养激活。
嘉宾-朋福东

相信面包的力量,建立国际“5D五感”面包实验室,用先进技术重铸烘焙商业市场。
中国烘焙名匠
面包研修社技术合伙人
首位华人世界面包双冠军
国家高级一级烘焙师
世界面包大使团成员
2009-2016年王森学院烘焙系主任
2016年至今 王森教育集团赛事委员会烘焙技术总监
2018德国慕尼黑iba世界面包锦标赛冠军
2018世界面包大赛六国精英赛冠军
第44届世界技能大赛烘焙项目专家组成员
第44届世界技能大赛烘焙项目国家队教练组组长
第44届世界技能大赛全国选拔赛教练
第45届世界技能大赛中国集训队教练组组长
2011年 上海FHC国际比赛 银奖
2017年 世界面包大赛中国区总冠军
2017年 法国世界面包大赛前六强
2017年 法国世界面包大赛艺术面包冠军
2017年 荣获江苏省人力资源和社会保障厅颁发的二等功勋章
2018年 德国慕尼黑iba世界面包锦标赛“最佳艺术面包奖”
2018年 世界六国精英赛最佳人气奖
什么是5D面包实验室

相信很多人都看过3D的、4D的电影。面包的世界也是缤纷有趣的,面包研修社将面包科学,转化为人体的五感:触觉、视觉、嗅觉、听觉、味觉。

触觉:质感、外观、手部感觉去体会,面包师的手就是缔造美味面包的秘诀。通过手部敏感的触觉,感受食材的温度、打面的最适状态、整形的排气量、发酵的湿度、温度的判断,烘烤熟成的状态等。
视觉:
制作面包中,通过观察食材、面团的状态,判断操作过程的最佳时间。不同面包的体系区分、诱人的外观吸引消费者购买,面包的质感增加艺术欣赏价值。中国消费者喜欢颜色鲜艳的点心式面包,丰富的奶油,水果,肉就非常受欢迎,以前日韩也一样,但是他们饮食文化已经不断改变,而这个改变需要更深入地了解面包,欧洲就推崇小麦的质感,朴实无华带来最震撼的面包本味。
嗅觉:对于面包师是非常重要的。
酵母的不同风味、也成就了面包的不同口味。在制作面团时,通过嗅觉去感受食材新鲜程度、感受面团的发酵状态,烘烤中美拉德反应产生的坚果香味、肉香味,既是面包师考量烘烤最适度状态,香味也能促进吸引消费者购买。
听觉:打面过程中面团和搅拌缸的声音能够判断面筋程度,制作欧式面包需要喷蒸汽,法棍等欧式面包出炉后的噼啪声也是判断面包内相组织的重要参考因素。
味觉:欧洲的面包更注重面包的风味,法国大多数面包都是酸的,他们对酸的需求超过亚洲。通过风味的感受,去判断一个面包的好坏。
美味与健康是现在消费者喜欢的面包。在比赛中,面包的口味也是占了最大的分数,面包是饱腹的食物,可以是主食,也能做日常的点心,可以一日三餐享用。Q弹的、松软的、香酥的、扎实的……不同口味的面包满足不同消费者的需求,而面包师的创作乐趣就在于,保留经典产品的同时,不断研发新的口味,传承与创新结合。
5D实验室发展计划
建立面包实验室、多媒体应用中心、面包感官实验室,陆续引进高端设备,对面包原料(麦子到面粉,酵母菌到商业酵母)、不同制程工艺等进行一系列的科学测试,由小原料至大设备做一个最完整的专业分析、研究。

例如面包研修社课程在实施的“吐司的奥义”,对吐司不同工艺、原料的测试实验课程。

面包技术的商业运用
1、将面包实验室的研发结果共享,运用于烘焙商业领域,通过科学的实验了解面包,从而研发更美味、健康、高效生产的面包。
2、建立面包科技馆、面包博物馆、面包亲子乐园,通过有趣浅显易懂的科普,让普通的消费者、民众了解面包、喜欢面包。

法国 MOF Mickaël CHESNOUARD

2011年获得法国MOF 头衔 ,面包研修社外教团队成员。
分享主题:丹麦面包的发展与创新
大西洋卢瓦尔省Loire-Atlantique 最佳学徒奖
2003年法国奥林匹亚职业大奖赛冠军
世界奥林匹亚职业大奖赛亚军
Mickaël Chesnouard 在2011年获得MOF头衔,这是由法国政府颁发的权威称号,是由法国总统颁发的“手工业者”的最高荣誉。(只有技术顶尖的职人才能得到MOF的殊荣,意味着拿到MOF就是行业的冠军。)
在法国atelier m'alice工坊担任培训师,面包咨询师;
2013年在全法顶级面包甜点学院前三强,法国顶级高等技术学校INBP担任特约老师。
丹麦起源

20世纪开始改变,增加了千层,口味也从甜变成咸的。
一个好的丹麦面包的要点是什么?
原料的重要性:

1.优质的小麦=优质的面粉

2.黄油

演变和趋势

2009年David Bedu发明了双色可颂,随着面包比赛的进行,可颂的形状、口味、颜色都有了演变发展。丹麦面包是面包和甜点之间沟通的桥梁,在丹麦可以看到各式各样的甜点奶油内馅。丹麦面包一直在发展,在目前也未停止发展和演变。
日本-土田耕正

他是星野天然酵母面包种取缔役技术部长,毕业于东京农业大学、以及美国面包制作学校。分享主题:味觉之王!日式面包口味的科学研发。
1985年 进入Rheon自动机株式会社,技术服务部
1989年 美国面包制作学校American Institute of Baking School毕业
1990年 为英国、意大利引进大型糕点生产线
1990年 Orange Bakery 第3工场项目成员
1992年 参与醒发后冷冻技术的开发,社内业绩收到表彰
1996年 Rheon USA(诺斯卡罗莱纳州)美国驻厂
2006年 全美各地工厂大型生产线导入、上线 从美国回国后就职海外课、往返出差赴美国、中国台湾、欧州各地进行大型制造线的产品测试、交货、海外展会等。
2017年 (有)星野天然酵母面包种 取缔役技术部长
美味的研究,日本发酵食品的根源和中国的酱(豆瓣酱、酱油)密不可分。发酵的的根源,追溯到中国隋唐时代,中国的酱油,连同佛教一起传播到日本;日本根据自己的理念,更改了发酵理念,味增。

未完全发酵的酱——味增
完全发酵得到—— 酱油
好吃的发酵食品取决于用传统的制法去制作,没有添加,天然的食材。现在面包的制作,是一个原点回归,未来的方向就是无添加又美味的食物。
世界发酵种总结

不同发酵方式
单发酵:单一微生物发酵
单一复发酵:一种菌用2个阶段来发酵
复试发酵:酒种
熟成的美味研究
1.食感:破断试验
咬面包的时候,前牙咬断,日本的检测仪器会有面包物理测试,亚洲人都喜欢先软后Q的口感,受面条米饭的口感影响,而欧洲是相反的。
2.香气成分(香气成分析)吟醸香
3.旨味:好吃度,自动氨基酸检测仪
氨基酸、琥珀酸对好吃度有非常多的作用。天然酵母的原种香气进行分析,评估苹果香、香蕉香,是对吟醸香的一种检测。

用使命感去做更好吃更健康的产品给孩子,将这种心态传承下去,我们的使命就完成了。
中国面包的未来

中国面包还有很大的发展空间,消费升级中,人们对高质量健康的面包有更多需求。中国预包装食品会有非常大的潜力,因为添加剂的使用仍然很大,在无添加的道路上,仍有更多研究的方向,回归自然,是未来趋势。

中国市场和欧洲市场不一样,而中国市场面包的口味结构仍然在不断变化更新,关注消费者动向,能更好找到发展趋势。中国过去的烘焙技术,更多从韩国、日本获得灵感,未来随着自主的研究、专业市场调研的陆续开展,会有越来越多的创新来自中国。
对于中国未来的烘焙市场,我们充满信心。